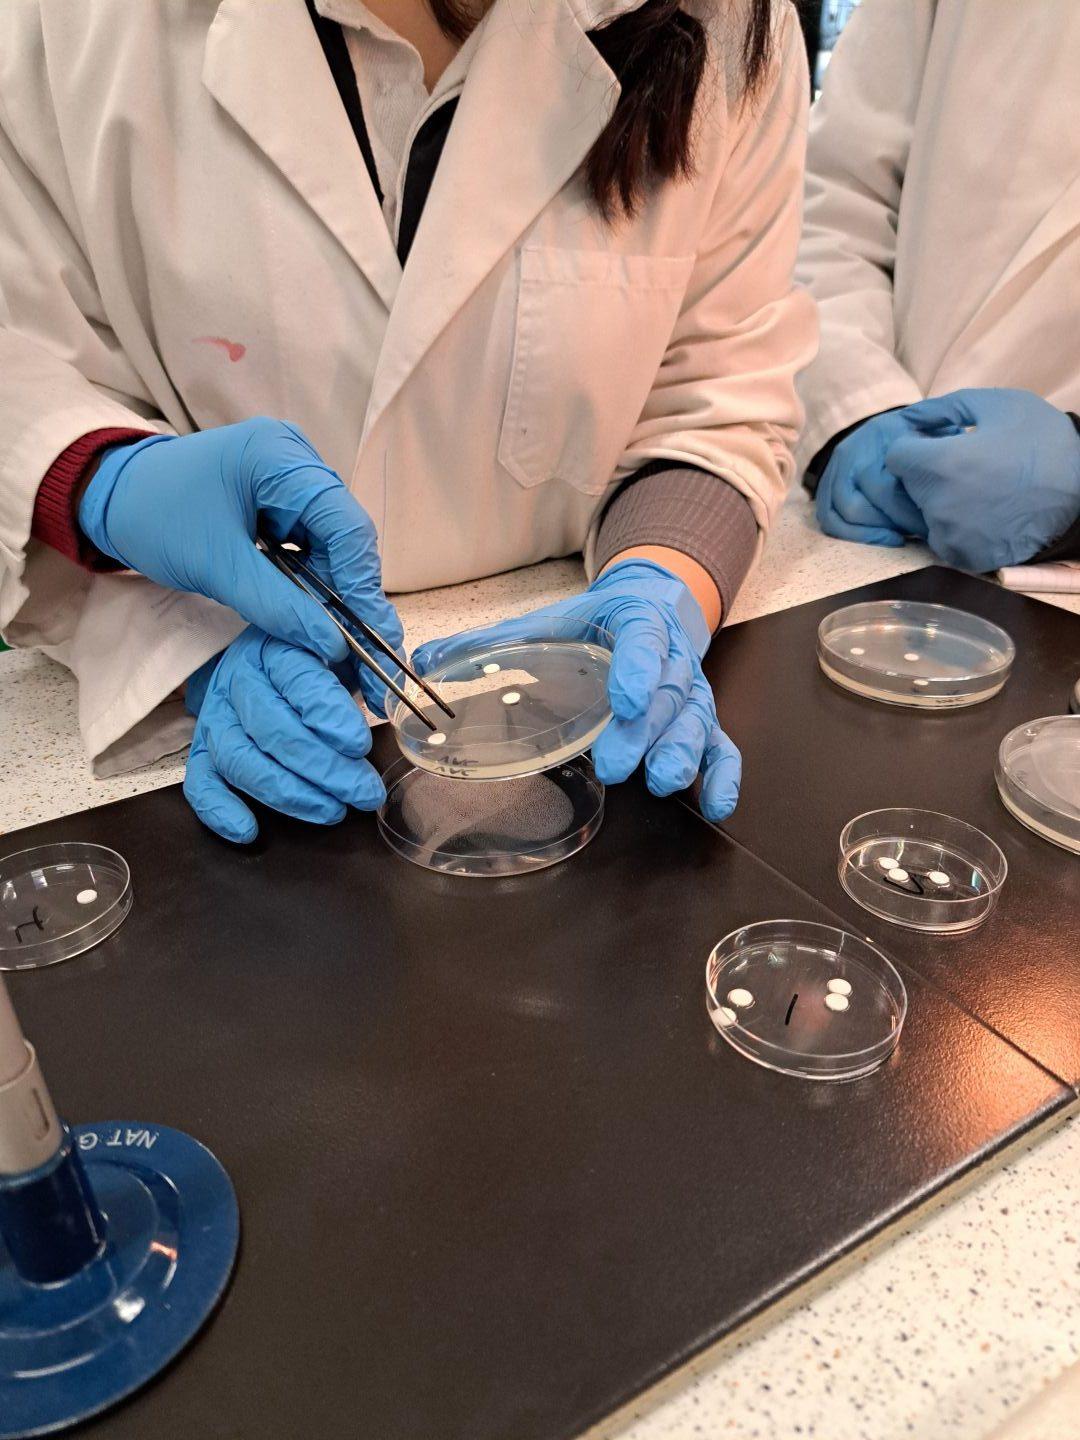
Biology2

Recently, Units 3 and 4 Biology students explored the fascinating world of immunity, discovering the world of pathogens and how the body protects itself from disease. We delved deep into learning about the modes of disease transmission, the first, second and third lines of defence and mechanisms to control the spread of harmful bacteria. To connect theory with practice, we conducted an experiment investigating the effectiveness of antibiotics. Using agar plates and bacterial cultures, we tested how different antibiotics inhibited bacterial growth. This hands-on experiment allowed us to observe first-hand how external measures, like antibiotics, support the body’s immune system by preventing harmful pathogens from multiplying. Additionally, we were able to enhance and improve our practical laboratory skills, practising our use of Bunsen burners and sterile techniques to ensure safety and hygienic practices.
We really enjoyed the opportunity to apply content to real-life scenarios, and found that participation in these practical activities strengthened our understanding of complex content.
Amelie B & Jasmine P (Year 12)